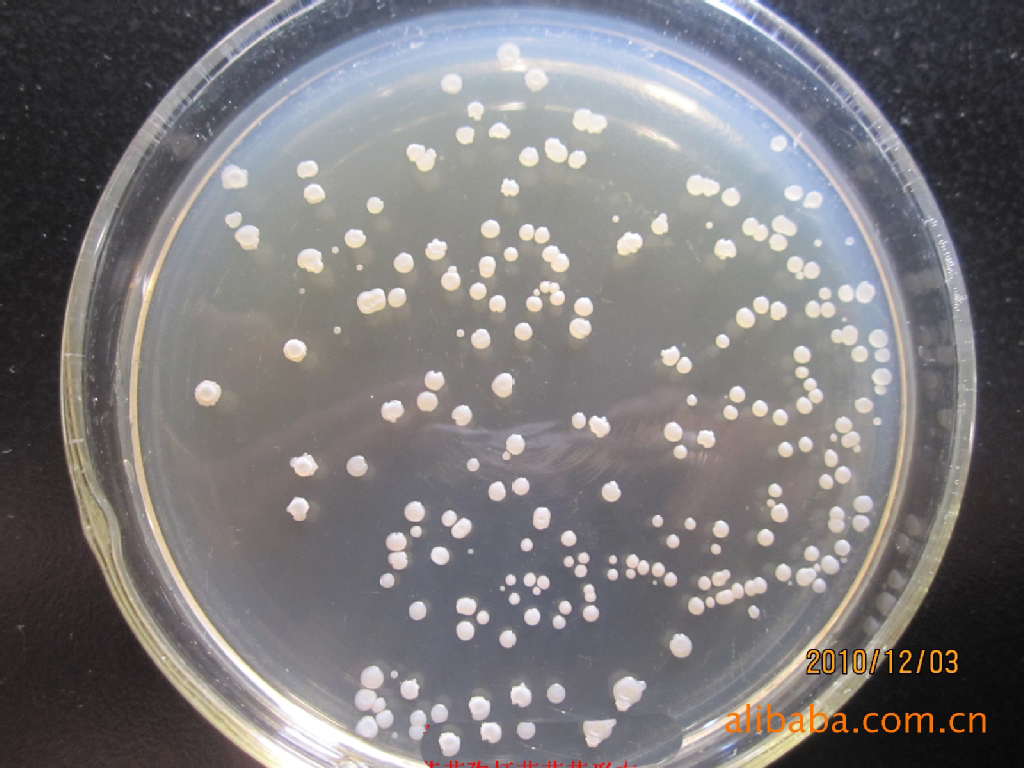
芽孢八叠球菌属
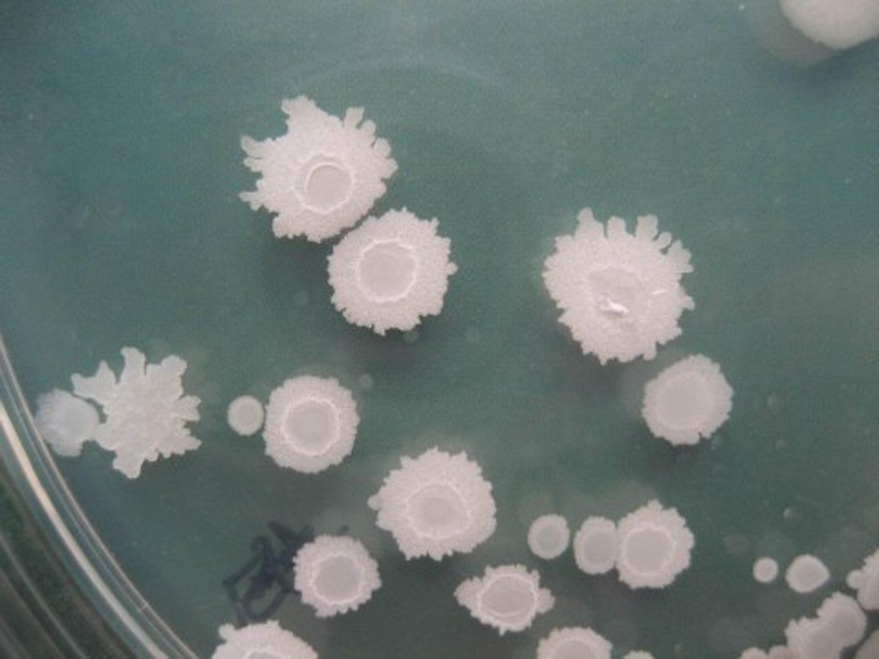
芽孢八叠球菌属
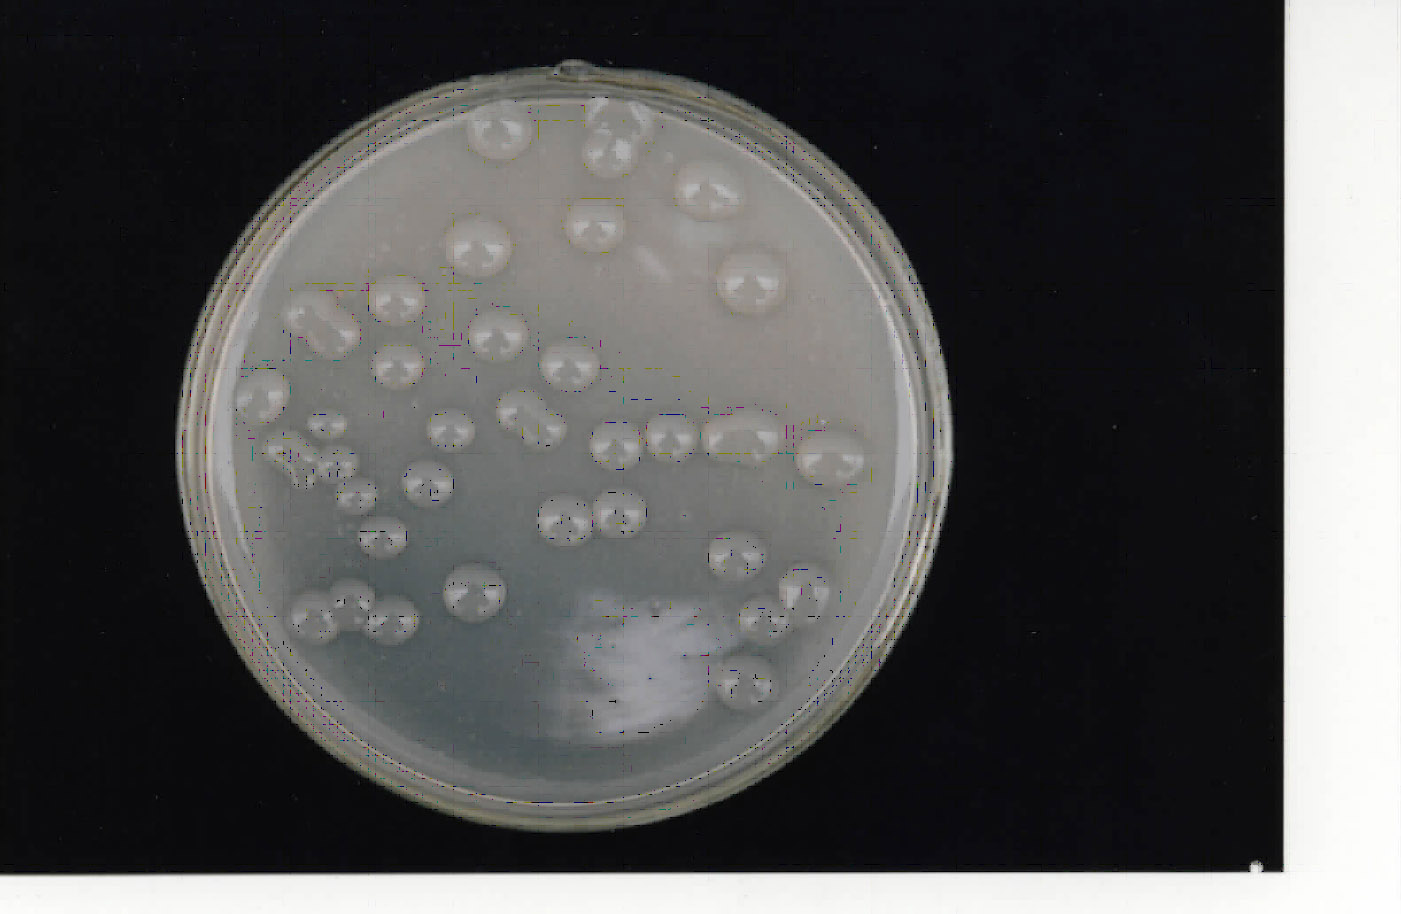
芽孢杆菌属

球形芽孢杆菌

球形芽孢杆菌_02_副本.jpg
图片尺寸750x918
球形芽孢杆菌
图片尺寸375x210
球形芽孢杆菌
图片尺寸300x357
球形芽胞杆菌——18h营养琼脂培养革兰氏染色
图片尺寸480x360
包邮 冻干粉 球形芽孢杆菌 atcc 4525 0代菌种培养服务
图片尺寸800x800
芽孢八叠球菌属
图片尺寸1306x879
球形芽孢杆菌水体灭蚊液 虫卵双杀除蚊子幼虫 水池鱼池池塘下水道
图片尺寸800x800
紫色球菌,芽孢杆菌,圆形弯曲细菌照片
图片尺寸300x300
【二手9成新】球形芽孢杆菌及其杀蚊原理和应用 (1995年) 科学 /张用
图片尺寸1200x900
芽孢八叠球菌属
图片尺寸1024x768
芽孢八叠球菌属
图片尺寸879x659
球形芽孢杆菌及其杀蚊原理和应用,张用梅主编,科学出版社
图片尺寸346x451
【二手9成新】球形芽孢杆菌及其杀蚊原理和应用 /张用梅 科学
图片尺寸1600x1600
永生|芽孢杆菌|细菌_新浪新闻
图片尺寸1150x758
空消球形芽孢杆菌灭蚊幼杀红线虫蚊幼孑孓蝇蛆杀幼蚊卵蚊子滋生地
图片尺寸800x800
芽孢杆菌属
图片尺寸1401x914
水池灭蚊剂球形芽孢杆菌杀虫剂鱼池鱼缸灭蚊子药除积水蚊子幼虫卵
图片尺寸800x800
芽孢杆菌
图片尺寸619x429
芽孢八叠球菌属
图片尺寸720x796
芽孢杆菌
图片尺寸640x474